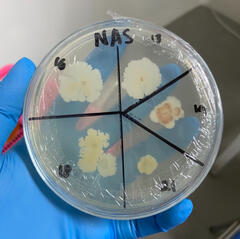
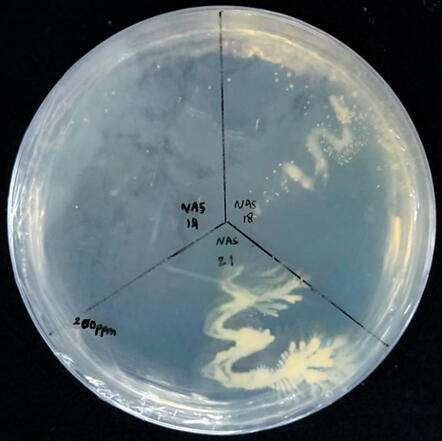

Yudhitia ganesha
she/her
biotech student • culinary and literature enthusiast • INTP
based in Semarang/Jakarta
iisma social campaign: batch 2, sdg 12

About
Biotechnology has always meant a lot to me, even as a childhood fantasy. Although curing the world from an alien-esque mutagenic disease would be an unlikely career in my lifetime, the prospects of biotechnology itself has so much to be explored. Currently, I am a third year student enrolled in a Biotechnology undergraduate program. My interests mostly revolve around biochemistry, molecular biology, extremophile microorganisms, and metagenomics.Aside from academics, I consider myself as an 'active' student: participating as committee in several events, submerging myself in student body organization and forums, as well as attending seminars and courses outside my major. I enjoy reading foreign books and writing poetry. In my 5th semester, I was named one out of ten Indonesian scholarship awardees for the Cargill Global Scholars Program.Please take a look below for more detailed information about me!
portfolio
poetry
I like to believe that those best-selling post-2010s modern poets start in the notes-app of their phones, so these are mine, compiled in a blog.

Academia
As a biotech major, I've been granted the opportunity to work on many things. I've been working as a laboratory assistant and I love helping my juniors that way. To this day I'm still proud of my research project, currently in drafts to be a published article!
experience

cgsp
The Cargill Global Scholars Program is a distinctive, leadership development program that provides financial support, leadership development training, and one-on-one mentoring. I am beyond grateful to be one out of 10 students in Indonesia to be able to bear the name Cargill Global Scholars proudly.
soc-pol

We inform the students on national political activity and we allow students to pass their opinions and critiques to us. As vice head, it was such a unique learning experience.
udf hrd

UDF is our university-scale debating community where the human resource department was needed to coordinate and accommodate our outstanding members. Being head was such an honor.
directory
social media & contact
featured documents